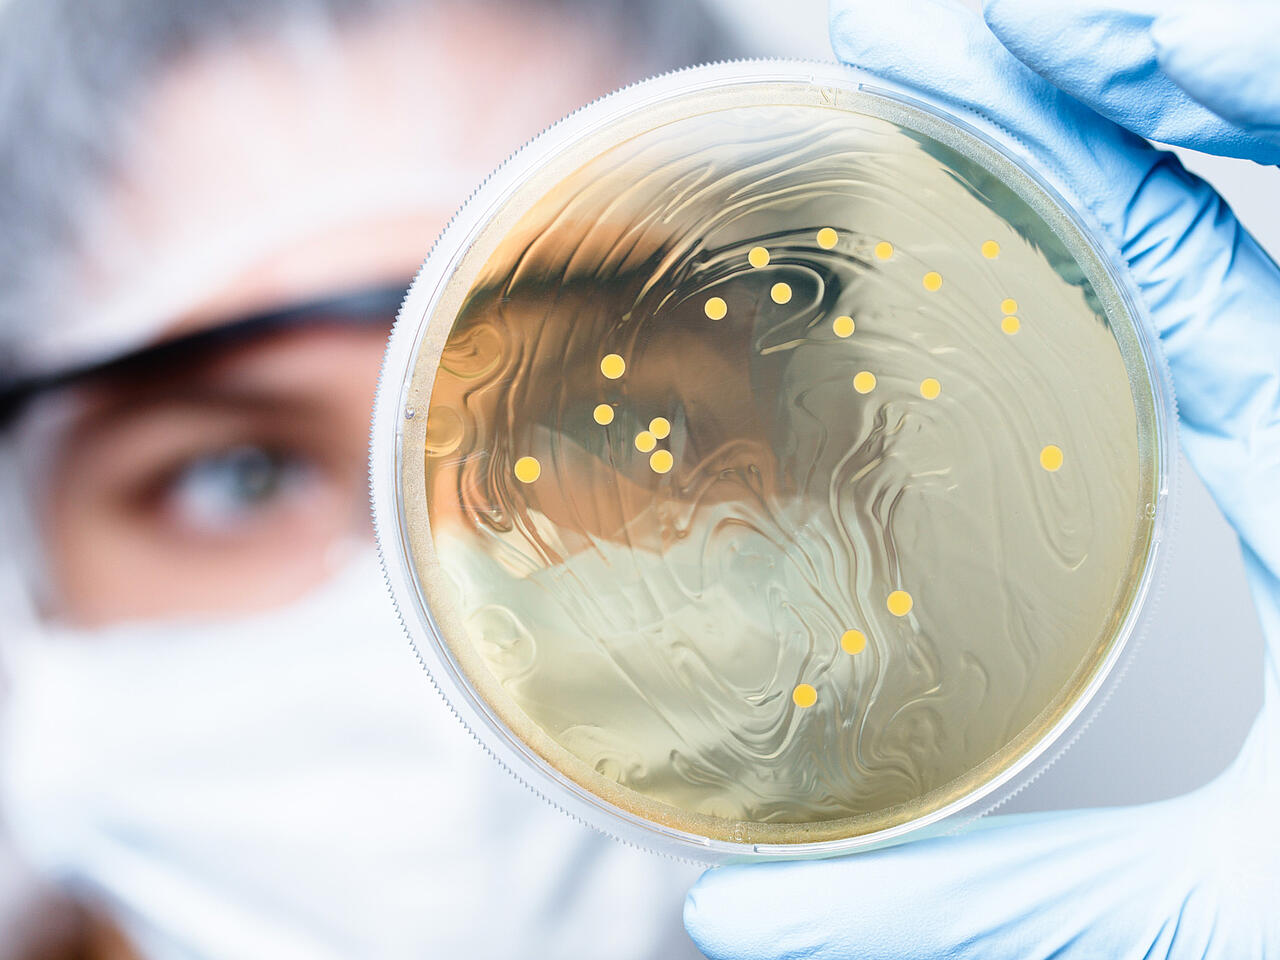
Researcher in the background with petri dish with bacteria in hand (foreground)

Our field of operation
Topas has been established on the American market for over 30 years with series devices and testing systems for classifying and testing filters and filter media. Our American customers can use this technology to verify their quality assurance, optimize their products, and expand their research.
oder
Since more than 30 years, technology-oriented particle, analysis and sensor systems have been developed, designed and manufactured under the name Topas. They can be used to generate, condition and analyse test and reference aerosols. In addition, more than 60 series devices and 20 test systems of our medium-sized Saxon company have been widely used and proven for the classification and testing of filters and filter media in worldwide industry and basic research for decades.
What's new in 2026?
Focus on customer benefits, sophisticated technical solutions, modern and handy design, flexibility in combination with other devices, and first-class service are all factors that our customers benefit from with every Topas device. You can discover a wide range of new developments in the areas of test systems and aerosol devices here and discuss them with our experts for your specific application.
Please contact us — we would be very glad to advise you on our new products:
Applications for our products
Events
We care.
Our most important goals are the development of innovative solutions and the implementation of customer requirements to their satisfaction. In the future, we would like to be even more of a problem solver for our customers - as a developer, manufacturer and distributor of advanced technologies.
Image brochure
Check our services
- repair & maintenance:
... for test systems, based on expert knowledge - consulting:
... on test results and standards - customer´s training:
... by personal demonstrating how our new test system works
... and a glimpse of the future:
- calibration and validation using proven Topas technology, made in Germany